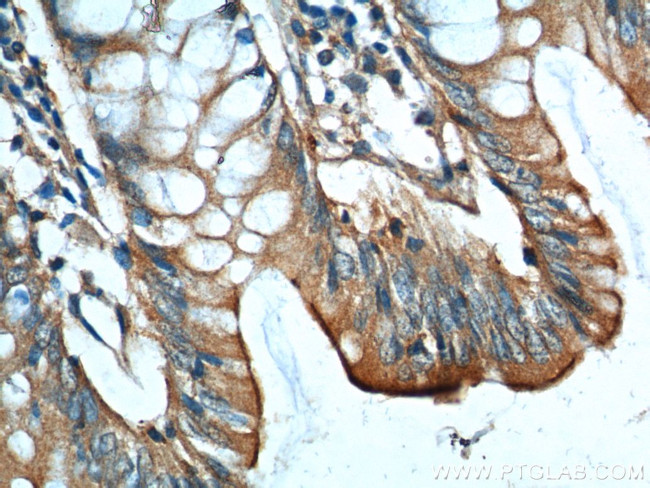
GIPR Antibody in Immunohistochemistry (Paraffin) (IHC (P))

Search
Proteintech
GIPR Polyclonal Antibody
{{$productOrderCtrl.translations['antibody.pdp.commerceCard.promotion.promotions']}}
{{$productOrderCtrl.translations['antibody.pdp.commerceCard.promotion.viewpromo']}}
{{$productOrderCtrl.translations['antibody.pdp.commerceCard.promotion.promocode']}}: {{promo.promoCode}} {{promo.promoTitle}} {{promo.promoDescription}}. {{$productOrderCtrl.translations['antibody.pdp.commerceCard.promotion.learnmore']}}
产品信息
18230-1-AP
种属反应
宿主/亚型
分类
类型
抗原
偶联物
形式
浓度
规格
纯化类型
保存液
内含物
保存条件
运输条件
产品详细信息
Immunogen sequence: TGSKGQTAG ELYQRWERYR RECQETLAAA EPPSGLACNG SFDMYVCWDY AAPNATARAS CPWYLPWHHH VAAGFVLRQC GSDGQWGLWR DHTQCENPEK NEAFLDQRLI LERLQVMYT (25-142 aa encoded by BC093723)
靶标信息
GIPR encodes a G-protein coupled receptor for gastric inhibitory polypeptide (GIP), which was originally identified as an activity in gut extracts that inhibited gastric acid secretion and gastrin release, but subsequently was demonstrated to stimulate insulin release in the presence of elevated glucose. Mice lacking this gene exhibit higher blood glucose levels with impaired initial insulin response after oral glucose load. Defect in this gene thus may contribute to the pathogenesis of diabetes.
仅用于科研。不用于诊断过程。未经明确授权不得转售。
篇参考文献 (0)
生物信息学
蛋白别名: Gastric inhibitory polypeptide receptor; GIP receptor; GIP-R; Glucose-dependent insulinotropic polypeptide receptor
基因别名: GIPR; PGQTL2
UniProt ID: (Human) P48546
Entrez Gene ID: (Human) 2696